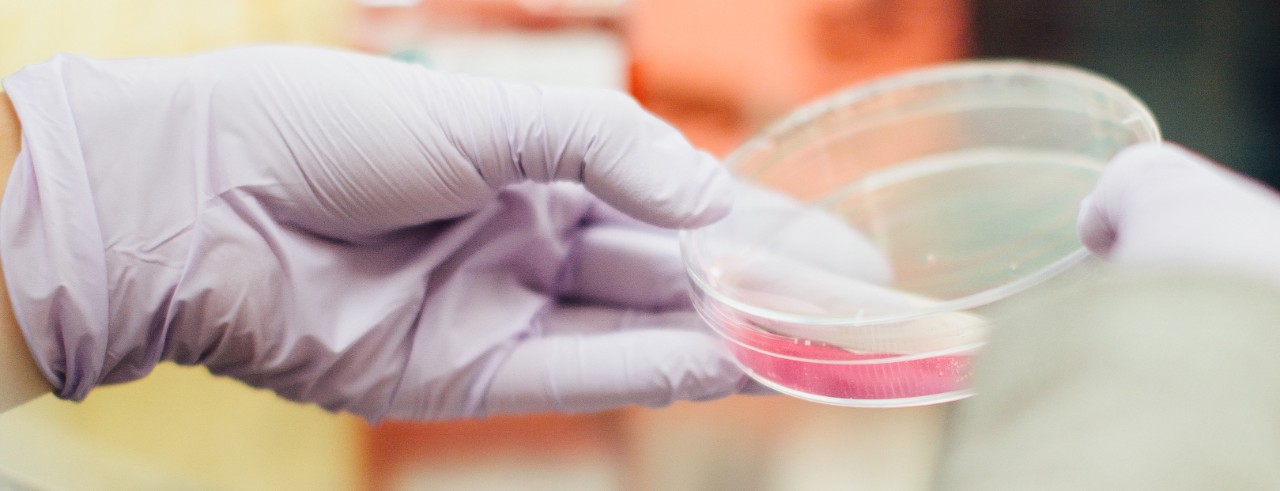
Petri dish

UC researchers study processes that cause breast cancer recurrence, spread
National Cancer Institute grant allows researchers to look at targeted treatments for breast cancer
One in eight women will be diagnosed with breast cancer in their lifetimes. Recurrence and spread are the biggest contributors to the death of these women.
That’s why Susan Waltz, professor in the UC department of cancer biology, is teaming up with other researchers at UC, Cincinnati Children’s Hospital Medical Center and the University of Kentucky to study the processes that cause these events to occur — and ways to both target and stop them.
The National Cancer Institute recently awarded this collaborative team a $500,000 yearly grant for the next five years to do just that.

Susan Waltz, professor in the UC department of cancer biology. Photo credit: Colleen Kelley/UC Creative + Brand
“The focus of this grant is understanding why some breast cancers come back after initial treatment and metastasize and others don’t,” says Waltz, the principal investigator on the study. “We identified two genes (RON and DEK) which are both found in human breast cancers. When both of these genes combined are seen in breast cancers, they are highly predictive of the cancers recurring and spreading.”
She says the teams are trying to uncover reasons these genes make breast cancer so aggressive and discover whether or not this knowledge can be used to predict which tumors are more likely to come back.
“We hope this will help us identify new vulnerabilities in these cancers — an Achilles’ heel, if you will — that can be used for the treatment of these aggressive cancers,” she says. “Our new data suggest that these genes rewire breast cancer cells to support unique energy needs of the cells by increasing cholesterol and glucose use required for tumors to grow and spread.
“In this study, we hope to map, at high resolution at the atomic level, the unique energy network driven by these two genes, with the goal of using this information to identify key nutrients that might both predict and be used to block breast cancers from coming back or metastasizing,” Waltz added.
“This could provide new ways to identify and treat potentially aggressive breast cancers at early stages, increasing survival and improving lives.”
Featured photo courtesy of Drew Hays/Unsplash
Next Lives Here
The University of Cincinnati is classified as a Research 1 institution by the Carnegie Commission and is ranked in the National Science Foundation's Top-35 public research universities. UC's graduate students and faculty investigate problems and innovate solutions with real-world impact. Next Lives Here.
Related Stories
Sugar overload killing hearts
November 10, 2025
Two in five people will be told they have diabetes during their lifetime. And people who have diabetes are twice as likely to develop heart disease. One of the deadliest dangers? Diabetic cardiomyopathy. But groundbreaking University of Cincinnati research hopes to stop and even reverse the damage before it’s too late.
App turns smartwatch into detector of structural heart disease
November 10, 2025
An app that uses an AI model to read a single-lead ECG from a smartwatch can detect structural heart disease, researchers reported at the 2025 Scientific Sessions of the American Heart Association. Although the technology requires further validation, researchers said it could help improve the identification of patients with heart failure, valvular conditions and left ventricular hypertrophy before they become symptomatic, which could improve the prognosis for people with these conditions.
Combination immunotherapy helps overcome melanoma treatment resistance
November 10, 2025
MSN highlighted research led by the University of Cincinnati Cancer Center's Trisha Wise-Draper showing a combination of immunotherapy medications can activate a robust immune response and help overcome treatment resistance in patients with refractory melanoma.
